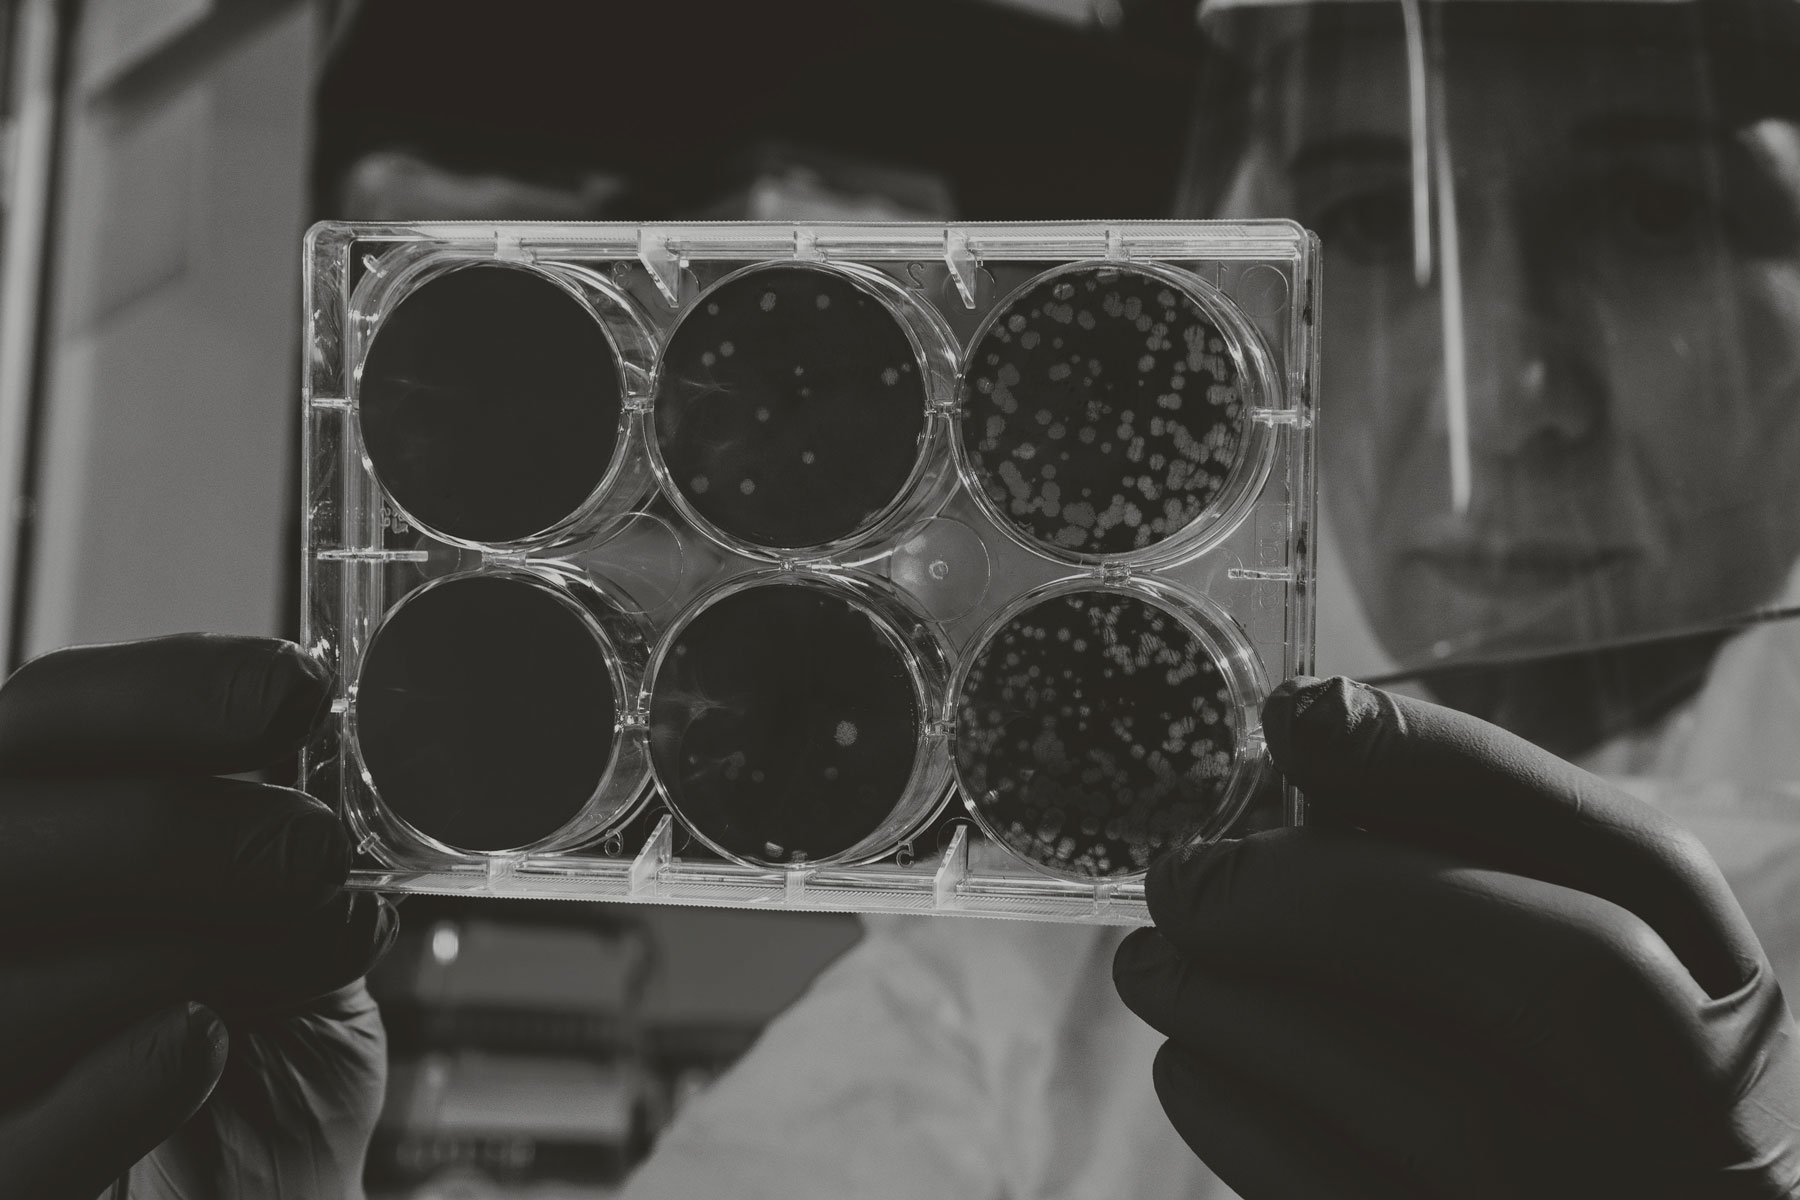

ENTREVISTES TALENT OSONA
DARRERES ENTREVISTES
PROJECTE DOT
TALENT D’OSONA
Des de Creacció, agència d’emprenedoria, innovació i coneixement, fa temps que tenim ganes de conèixer i establir contacte amb persones d’Osona que desenvolupen la seva trajectòria professional fora de la comarca per connectar-la amb el territori.
En aquest sentit neix el projecte DOT (Talent D’Osona) que pretén ser el punt d’unió d’aquest talent amb la comarca. La finalitat és posicionar l’ecosistema del coneixement de la comarca i incorporar-lo als diferents projectes de desenvolupament local d’Osona.

DOT és talent arrelat a Osona, és el punt d’unió entre aquest i el seu origen, és l’espai per crear sinergies i compartir-les.
DOT és talent arrelat a Osona, és el punt d’unió entre aquest i el seu origen, és l’espai per crear sinergies i compartir-les.
ECOSISTEMA DOT
SUMA-T’HI
Ets osonenc o osonenca i ara mateix estàs desenvolupant la teva carrera professional fora de la comarca? Suma’t a l’ecosistema DOT!
Volem ampliar l’ecosistema del coneixement d’Osona i estem convençuts que les vostres experiències, coneixements o trajectòries professionals poden ser molt inspiradores i motor de nous projectes amb impacte a la comarca!












